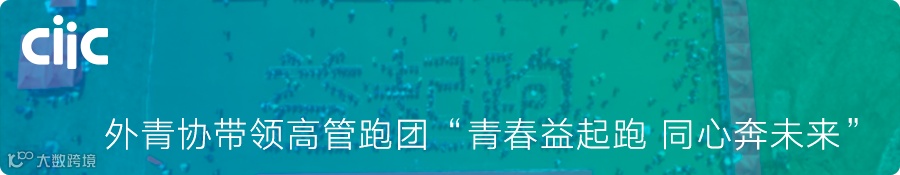

数字正以一种不可逆的姿态深入我们的生活、工作。大家可以在各大新兴网络平台解决大部分的生活、娱乐需求;平台也引领着越来越便捷、高效的生活方式。数字商业的破势之力已不容小觑。那么,如何拥抱数字化时代的创新冲击?
上海外企青年人才协会作为主办单位之一,于7月30日开展《解读数字商业破势之力》沙龙活动,邀请了来自Bilibili、得物、三井住友海上火灾保险等公司的嘉宾分享见解。
WORDS
文本字数:1390
TIME
建议阅读时间:6分钟
TARGET
建议阅读人群:想要了解数字商业的你

上海外企青年人才协会介绍
活动伊始,上海外企青年人才协会副会长、三井住友海上火灾保险(中国)有限公司副总经理兼CFO郑永强向嘉宾介绍了协会。作为连接政府与外企、优化上海营商环境的有效桥梁,协会取外企之长,集青年之力,聚人才之智,围绕“提供沟通学习机会”、“搭建新技术展示平台”、“建言献策城市发展”、“服务举荐青年人才”、“扶贫帮困志愿服务”、“组织国际青年交流”等任务,重点在服务、凝聚、宣传、培养和举荐外企优秀青年人才方面开展工作,旨在凝聚外企青年人才力量,为更好地促进上海经济和社会建设贡献智慧和力量。
此次组织《解读数字商业破势之力》沙龙活动,是协会聚焦热点话题,汇聚多元观点的具体尝试。
活动现场,嘉宾金句频出,让我们一起来看看都有哪些精华内容吧!

内行人教你如何玩转B站
Bilibili 营销总监
张庆
根据QuestMobile统计,B站是中国24岁以下年轻人偏爱的APP。张庆介绍道,在B站,“内容即商业、商业即内容”。B站吸引了大量的内容创作者,由专业个人用户创作的视频,占据最吸引B站用户观看视频的91%。B站UP主的营销完全基于自身兴趣,活跃的UP主创作生态是社区不断发展的动力,给内容营销提供了更多的可能。
在用户的推动下,B站已经成为众多网络流行文化的发源地。比如,“弹幕”“梗”“鬼畜”“种草”等都是出自于B站。张庆幽默风趣的演讲也收获了一大批粉丝,很多原先不曾接触B站的嘉宾也纷纷拿出手机下载了B站,并通过考试成为了B站的新会员。

年轻人都爱的潮牌
是如何运营的?
得物 高级财务总监
瞿孜文
作为新一代潮流网购、生活社区,得物APP聚集了新、潮、酷、炫的各类商品,也聚集了一大批热爱潮品穿搭和文化的用户。通过“社区+电商”双业务模式,得物APP逐渐占领年轻人市场。据人民网报道,每3个年轻人就有1个使用得物APP。
得物的财务部门更是通过数字化手段实现了业财融合的生态创新。从复杂到简单,从简单到自动,再从自动到智能,通过数据中台建设,得物实现了智能财务管理;通过财务数字化,做到了Fast-Closing,数据结果可比、可细化、可追溯,同时实现了数据的商业智能展现;通过财务管理模式转型,将财务功能前置,深度业财融合,实现了导航灯型财务管理能力;最终实现了从认知到感知再到决策和行动的财务价值链变革。

数字金融背景下的传统企业
如何实现完美转型?
三井住友海上火灾保险
副总经理兼CFO
郑永强
郑永强总结了传统行业如何在数字化时代进行变革创新的经验。他认为,科技将极大地改变传统企业的内部管理,自动化、智能化和数字化将是未来企业管理的方向。运用“ABCD”技术,将极大程度降低企业内部运营成本,同时大幅提高企业营运效率,人机互动和人机结合将是企业的未来。
郑永强也展示了公司正在使用的新型“报销助手”机器人,极大程度减轻了申请人的工作量,只要拍照和简单的言语,就可以完成繁杂的报销工作;同时,也通过机器人,在财务审核方面强化并前置了内部控制和风险管控,通过“0”人工干预的方式,极大程度的提高了运作效率。
最后,作为财务数字化转型前沿的排头兵,PwC智能化项目负责人Helen向大家介绍了企业未来资金管理的变革,以及微丘智能的RAAS解决方案,利用现金机器人助力企业解决资金管理的痛点,为企业智能化发展提供优质解决方案。
特别鸣谢澳洲注册会计师协会、君澜律师事务所、微丘智能、旺旺集团为本次活动提供大力支持。
关于协会